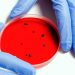
Cos'è la malattia mangiacarne e quali sono i sintomi? Ecco tutto quello che c'è da sapere

Roma è pronta a ribadire, ancora una volta, il ruolo di capitale mondiale dello skateboard: dal 18 al 25 giugno, infatti, i migliori skater del mondo si sfideranno nel rinnovato Skatepark del Parco del Colle Oppio, all’ombra del Colosseo, per una tappa del World Skatebording Tour 2023 che assegnerà anche punti utili in vista delle qualificazioni verso i Giochi Olimpici di Parigi 2024. “Siamo ormai diventati la Wimbledon dello skateboard”, ha esordito Sabatino Aracu, presidente World skate e FISR, durante la presentazione alla stampa della tappa organizzata nella Capitale. Sulla scia del grande successo dei mondiali Street 2021, svolti nel Parco del Foro Italico di Roma e della tappa successiva dello scorso anno al Colle Oppio, la Città Eterna ha consacrato il suo ruolo di capitale mondiale dello Skateboarding. Quest’anno ci sarà anche il mondiale Park ad Ostia ma il prossimo ci sarà il botto per la città eterna, che ospiterà i due mondiali di Street e di Park in occasione dei World Skate Games 2024 assegnati all’Italia.
“Questa tappa, valida per la qualificazione alle Olimpiadi di Parigi 2024, è la dimostrazione che Roma può recitare un super ruolo perchè dopo Colle Oppio andremo a Ostia, dimostrazione che noi tutti crediamo in questo sport”, ha aggiunto Alessandro Onorato, assessore allo sport di Roma Capitale. Come cornice per l’edizione 2023 è stata scelta anche quest’anno la collinetta del parco del Colle Oppio sovrastante l’Anfiteatro Flavio, luogo di straordinaria bellezza ed unicità, nel quale si sfideranno i 275 atleti partecipanti (83 donne e 192 uomini), provenienti da 57 paesi di tutti i cinque continenti. Lungo i lati lunghi dello skatepark sono state allestite due tribune (Colle Oppio e Colosseo) con una capienza di 1.300 spettatori paganti. La venue, invece, potrà ospitare fino a 2500 persone al giorno che avranno a disposizione un palinsesto di attività extra sportive dedicate.
“L’emozione di essere qui a Colle Oppio è impareggiabile perchè qui siamo riusciti a realizzare una magia trasformando un luogo iconico in uno ancora più iconico.
Questo fine a qualche mese fa era un luogo di dolore, ora è un’appendice del Foro Italico utilizzato da giovani e turisti, un modello virtuoso di rigenerazione urbana”, le parole di Vito Cozzoli, presidente e AD di Sport e Salute. L’evento fa parte di un progetto congiunto tra la Federazione Internazionale World Skate, Sport e Salute e la Federazione Italiana Sport Rotellistici, sotto l’egida del CIO, e proseguirà anche nei prossimi anni, con la città eterna che ospiterà fino al 2025 una delle tappe del “World Skateboarding Tour Street”.
– foto spf/Italpress –
(ITALPRESS).